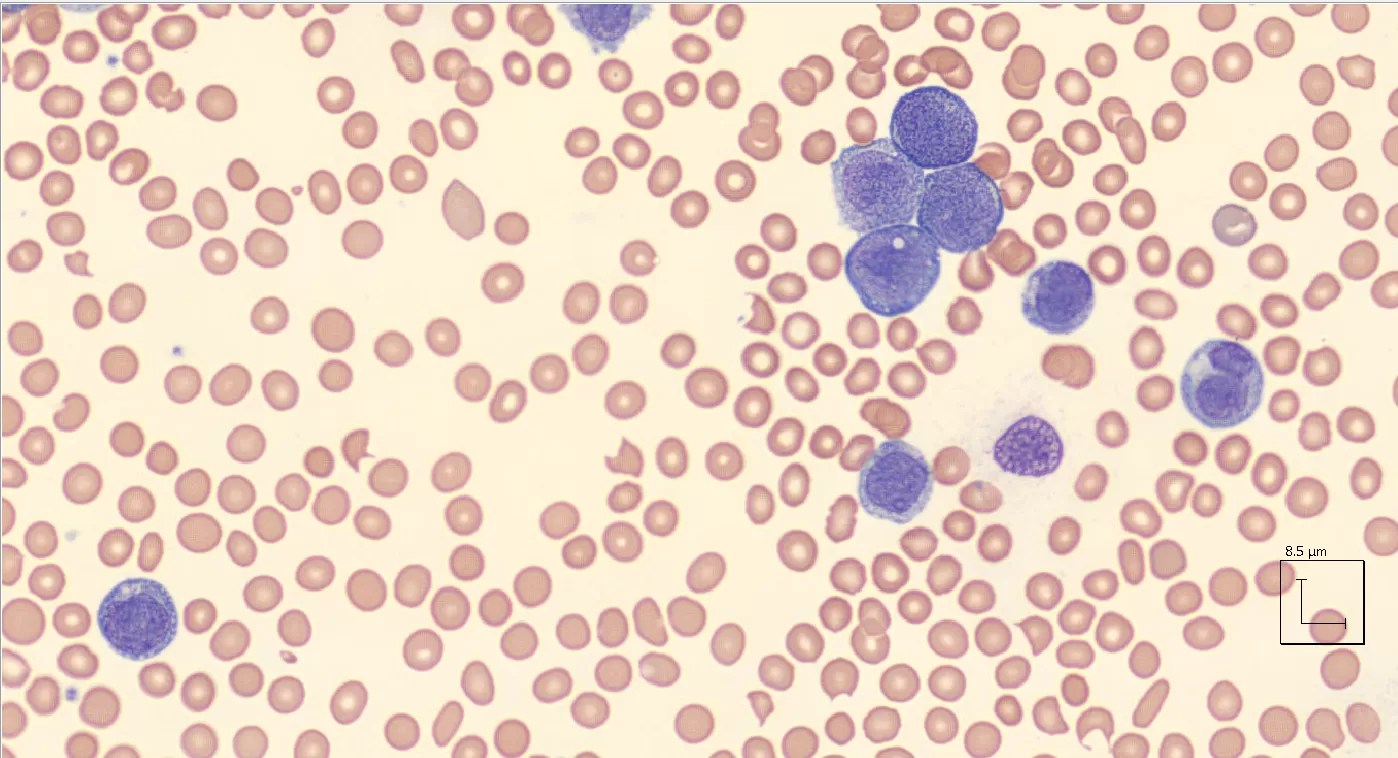

Evaluation of the Peripheral Blood Smear

Learn about the essential equipment, preparation steps, and systematic approach for interpreting peripheral blood smears—a vital clinical diagnostic tool

Learn about the essential equipment, preparation steps, and systematic approach for interpreting peripheral blood smears—a vital clinical diagnostic tool
Peripheral smear from a 90-year-old female who presented to the hospital with confusion and shortness of breath and was found to have a significantly elevated white blood cell count to 140 K/UL, hemoglobin 9.1g/dL, and platelets 52 K Her differential…

Peripheral smear of a patient with a history of prostate cancer and admitted with liver failure and signs of liver disease. His laboratory workup showed signs consistent with hemolysis and his smear seen above showed marked red blood cell abnormalities.…